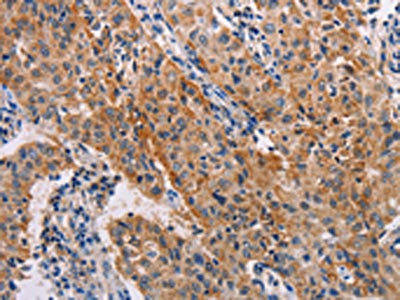

ADH1A Antibody
-
中文名稱:ADH1A兔多克隆抗體
-
貨號:CSB-PA233146
-
規格:¥1100
-
圖片:
-
The image on the left is immunohistochemistry of paraffin-embedded Human lymphoma tissue using CSB-PA233146(ADH1A Antibody) at dilution 1/20, on the right is treated with fusion protein. (Original magnification: ×200)
-
The image on the left is immunohistochemistry of paraffin-embedded Human lung cancer tissue using CSB-PA233146(ADH1A Antibody) at dilution 1/20, on the right is treated with fusion protein. (Original magnification: ×200)
-
Gel: 10%SDS-PAGE, Lysate: 40 μg, Lane 1-4: human fetal liver tissue, Human liver cancer tissue, mouse liver tissue, human hepatocellular carcinoma tissue, Primary antibody: CSB-PA233146(ADH1A Antibody) at dilution 1/250, Secondary antibody: Goat anti rabbit IgG at 1/8000 dilution, Exposure time: 10 seconds
-
-
其他:
產品詳情
-
Uniprot No.:
-
基因名:ADH1A
-
別名:ADH alpha subunit antibody; ADH antibody; ADH1 antibody; ADH1A antibody; ADH1A_HUMAN antibody; Alcohol dehydrogenase 1 (class I), alpha polypeptide antibody; Alcohol dehydrogenase 1 antibody; Alcohol dehydrogenase 1A (class I), alpha polypeptide antibody; Alcohol dehydrogenase 1A antibody; Alcohol dehydrogenase subunit alpha antibody; Aldehyde reductase antibody
-
宿主:Rabbit
-
反應種屬:Human,Mouse
-
免疫原:Fusion protein of Human ADH1A
-
免疫原種屬:Homo sapiens (Human)
-
標記方式:Non-conjugated
-
抗體亞型:IgG
-
純化方式:Antigen affinity purification
-
濃度:It differs from different batches. Please contact us to confirm it.
-
保存緩沖液:-20°C, pH7.4 PBS, 0.05% NaN3, 40% Glycerol
-
產品提供形式:Liquid
-
應用范圍:ELISA,WB,IHC
-
推薦稀釋比:
Application Recommended Dilution ELISA 1:2000-1:5000 WB 1:500-1:2000 IHC 1:25-1:100 -
Protocols:
-
儲存條件:Upon receipt, store at -20°C or -80°C. Avoid repeated freeze.
-
貨期:Basically, we can dispatch the products out in 1-3 working days after receiving your orders. Delivery time maybe differs from different purchasing way or location, please kindly consult your local distributors for specific delivery time.
-
用途:For Research Use Only. Not for use in diagnostic or therapeutic procedures.
相關產品
靶點詳情
-
基因功能參考文獻:
- High ADH expression is associated with Prostate Cancer. PMID: 28870918
- Results suggest a potential role of alcohol dehydrogenase (ADH) class I as a marker for renal cell carcinoma (RCC). PMID: 27086037
- Data indicate that the up-regulation of aldehyde dehydrogenase-1 (ALDH1) after neoadjuvant chemotherapy (NAC) predicts poor survival in locally advanced breast cancer. PMID: 24762066
- Unde-rexpression of the ADH1 gene, which influences the transformation of the extracellular matrix, plays a probable role in the etiology of uterine fibroid. PMID: 23891545
- high levels of ADH1 transcription are implicated in fluconazole resistance in C. albicans and that the mRNA expression levels of ADH1 are positively correlated with those of CDR1, CDR2 and FLU1. PMID: 23769565
- common ADH variants conferred risk for both schizophrenia in African-Americans and autism in European-Americans. PMID: 23468174
- High ADH1 is associated with endometrial cancer. PMID: 20872569
- ADH1A variation predisposes to personality traits and substance dependence PMID: 19526455
- Structural aspects that influence dimer-tetramer formation. PMID: 12081471
- GATA-2 and HNF-3beta regulate the human alcohol dehydrogenase 1A (ADH1A) gene. PMID: 16153155
- The oxidative pathway of ethanol metabolism via ADH and ALDH does not play a role in pancreatic carcinogenesis. PMID: 17632320
- Alleles of ADH7 SNPs were associated with the early stages of alcohol metabolism, with additional effects in the ADH1A, ADH1B and ADH4 regions. PMID: 19193628
- Observational study of healthcare-related. (HuGE Navigator) PMID: 15279067
顯示更多
收起更多
-
亞細胞定位:Cytoplasm.
-
蛋白家族:Zinc-containing alcohol dehydrogenase family
-
數據庫鏈接:
Most popular with customers
-
-
YWHAB Recombinant Monoclonal Antibody
Applications: ELISA, WB, IHC, IF, FC
Species Reactivity: Human, Mouse, Rat
-
Phospho-YAP1 (S127) Recombinant Monoclonal Antibody
Applications: ELISA, WB, IHC
Species Reactivity: Human
-
-
-
-
-